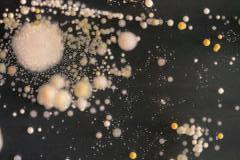
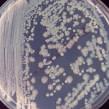
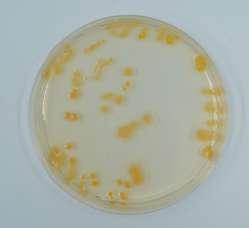
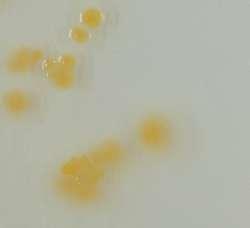
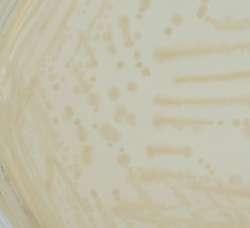

Site:Jakarta, Indonesia
Individual Work
2023.11-2024.1
Climate change is a global issue that may seem distant, but proactive measures should be taken to mitigate its potential impacts. This project envisions a hypothetical scenario where Jakarta, Indonesia, could face challenges of land submersion due to rising sea levels caused by climate change by the year 2100. As the world's largest exporter of coconut products, Indonesia generates a significant amount of coconut shells as waste, often burned. However, coconut shells are, in fact, a sustainable and renewable building material.
Simultaneously, we take inspiration from the indigenous maritime community of the Bajo people, utilizing them as a model for sustainable and resilient urban migration. In this context, the goal is to explore innovative methods, leveraging renewable resources such as coconut shells, to establish a more flexible and sustainable urban development model. Through adaptive measures to rising sea levels and the integration of local culture, the aim is to provide a comprehensive solution, laying a solid foundation for the future development of Jakarta.












































FUNCTIONAL AREA GENERATION LOGIC MASTER PLAN






LEARNING LIKE THE BA YAO ETHNIC GROUP
RESEARCH ON RESIDENTS' LIVING HABITS MODULAR BLOCK GENERATION LOGIC



























































































Utilizetheecosysteminwaterbodiestoprovidea growthenvironmentforfish,whilealsoproviding thenutrientsneededforcropgrowth.
AGRICULTURE(FISHING,PLANTING)


POWERPLANT
Theuseoftidalmotiontogenerateelectricity ensuresstableproductionoperations
ECONOMICINDUSTRIALZONE(PROCESSING,MARKET)
Centralizedmanufacturingandproductionbusiness areas,ensuringcoordinationandcooperationbetween differentindustriesandservices
Convenientforworkingpeople toquicklyaccessservices
ASSEMBLYSPACE(GATHERING,PRAYING)
Storage



facilities,Providebasicfacilitiessuchasschoolsandmedical activitiesutilizeopenoceanspacesforcommunity andculturalperformances.

POWERPLANT

ECONOMICINDUSTRIALZONE(PROCESSING,MARKET)
WATERRESOURCESCENTER
Microfiltration disinfection
Coarsescreening
market,Residentscanquicklyreachthe convenienceandlandhasimprovedthe ofresidents
sewage
sewageAbsorbseawaterandcollectdomestic fromresidentstopurifyitinto purewaterandcollectitforcirculation.
Utilizingwindpowergeneration andstoragetoachievesustainable electricityconsumption

WATERCOLLECTIONDEVICE
Responsibleforstoringfilteredwater toavoidwatershortagesduringpeak periodsfordomesticuse
moreBeingclosetolandmakesthetransportationofgoods convenient.Promotedeconomicexchangebetween maritimecitiesandland. Efficientandcompactstructurethatintegrates residentialareasandreducestransportation demand.
andTheportareathatprovidescargohandling,warehousing, logisticsservicesservesasakeynodefortrade betweenthecityandotherregions.

RESIDENTIALSOCIALIZING


Ensure that residents in public service areas have convenient access to various public services.



This area is used for industrial and production activities and requires convenient transportation and logistics networks to support production activities.













This area is mainly used for residential purposes, emphasizing the quality of life and convenience of residents.



This area is the commercial and economic center of the city, and the core of its commercial activities and economic development.
The roof is equipped with solar panels, which can meet the electricity needs of households, and the excess is stored in household batteries

STEP1

STEP2
STEP3
Building the first floating island from a city like the ocean
Floating islands slowly fill both sides of the coastline
Floating islands become part of land and attempt to expand outward
RESILIENT +MODULAR
STEP4
Construction process
Starting from local materials
Use Process
Sustainable recognition
Future development
Powerful scalability
Sustainable Coconut Island Roaming at Sea
SUSTAINABLE COCONUT ISLAND
SOCKETS AND EDITABLE
Supporting structure
Detachable
Residential unit
Flexible choice
Public utilities
Match according to needs
Sustainable Coconut Island expands through a "common language" by reusing recyclable materials to expand or shrink space based on population, needs, ecology, and environment. Not only contribute to the well-being of residents, but also contribute to the sustainable development of ecology.

Design Of Long Span Buildings
Site:Hangzhou, China
Individual Work
2023.06-2023.09
The project is located by the Qiantang River in Hangzhou. For people living in the south of the Yangtze River, the rainy climate is a headache, which also makes it difficult for spectators to watch sports events on rainy days. Therefore, I started by studying the structure, material and mechanical properties of umbrellas, which are essential for people in rainy days, to find the commonalities of umbrellas.
On this basis, I used the light weight and toughness of umbrella bones to construct the opening and closing structural system of the stadium cover. In studying the structural system, I applied machine learning methods such as KARAMBA Mechanical Analysis and OCTOPUS Multi-Objective Optimisation to ensure the rationality and optimality of the generated building structure.
This system is flexible and collaborative, allowing for freer opening and closing in all weather conditions, allowing the venue to host events and even concerts in all weather conditions.










Henri Lefebvre believes that space is constructed by human perception and experience, and is an important component of human culture. He also believes that different types of space are interrelated and together constitute human spatial experiences.
Matthias Weischer believed that space is constructed by human perception and experience, and is an important component of human culture. He also believes that different types of spaces are interrelated and together constitute human spatial experiences.
Gaston Bachelard emphasizes that space is not only the location of physical entities, but also a spiritual place that can influence human emotions and consciousness, and can be expressed and explained through poetry, art, and science.
Gaston Bachelard emphasizes that space is not only the location of physical entities, but also a spiritual place that can influence human emotions and consciousness, and can be expressed and explained through poetry, art, and science.
Operational Difficulty
Openness
City Stadium
Open External Space Facilities
Emphasize Internal Venue Experience Change
Efficient Planar Organization
Flexible Spatial Layout Diversity
Contact
The completed large-scale sports building is a entity for the external space,separating the internal and external activities.
The completed large-scale sports building is a entity for the external space, separating the internal and external activities.
Public spaces are attached around the venue, which may be small sports centers or leisure spaces, and they may be idle
Public spaces are attached around the venue, which may be small sports centers or leisure spaces, and they may be idle
When alarge volume is insented into an open playground,the open space is compressed into a ring
When alarge volume is insented into an open playground,the open space is compressed into a ring
Solid Centre Ancillary Space Breaken Public Space Negative Barriers
After a building becomes an immortal entity, it becomes a symbolic center.
After a building becomes an immortal entity, it becomes a symbolic center.
A transparent space,inside and inside,inside and outside can be seen each other
A transparent space, inside and inside,inside and outside can be seen each other
Typically the nearest touchline, or outside lane of running track, or boundary of area of activity
Point of focus
Key to diagram:
X: Distance from viewpoint
Y: Height from viewpoint
K: Number of rows within a segment
At the same time, this is a closed ring, and the line of sight and moving line are blocked ,and such a narrow and narrow space is not conducive to stimulating communication and activities.
At the same time, this is a closed ring, and the line of sight and moving line are blocked ,and such a narro space is not conducive to stimulating communication and activities.
A sports and public sports stadium usually has a portion raised and another portion sunk underground
Void Centre Positive Connect Seperation Attribute Spatial Continuity
A sports and public sports stadium usually has a portion raised and another portion sunk underground
Using ramps instead of flat surfaces in internal public spaces can increase coherence and openness
C: Line of sight rise value C
Using ramps instead of flat surfaces in internal public spaces can increase coherence and openness X
If spectators stand, they will, with the exception of the front row, experience a significant deterioration in the sightlines and "C" value. The focal point will move further away, usually into the activity area.
Note:
Designers should consider potential problems for other spectators when viewing from the sides and at high levels For reasons of clarity, all handrails have been omitted from the diagrams


I took inspiration from the umbrella scissor structure and further developed this system to help people better understand the functionality and performance of stadium roofs.
Umbrella opening and closing diagram
1.Fixed bottom

Ensure fixation at the bottom
Structural mechanical properties
skeleton under rain film
Connect the tips. The hinge joint is the maximum stress and deformation point under the action of wind force, and the mechanical performance of the hinge joint is better than that of the welded joint.
Improvement and optimization

The principle of opening and closing :B slides along shaft toward A, resulting in the deformation of triangle ABb, parallelogram baC,C2 parallelogram cC2dD and E in the plane away from the shaft.
We achieve the opening and closing structure by controlling two points B and C. According to the force analysis, we need to add rods at points C and E to resist tension, and we need to add expandable rods at points B and D to resist pressure.

2.Push the sliding rod

3.Fixed sliding rod

Push the slider to slowly unfold the umbrella surface Ensure that the umbrella surface is fully folded and secure it



Original Structure Optimizing institutions
The distribution of stress is similor for long umbrella ond folding umbrella, with stress concentroled at the intersecion of ribs. The closer to the end of the ribs, the higher the degree of displacement, reaching the maximum at the tip umbrella and folding umbrella, with stress concentroled at the intersecion of ribs. The closer to the end of the ribs, the higher the degree of displocement, reaching the maximum at the tip.







3 4 5 6
Activity structure
1:Secondary strut
2:Main support rod
Fixed structure
3:Tie rod
4:brace
5:brace
6:Big arm
From the moment they begin to unfold, umbrellas emit a unique magic that transforms outdoor space into indoor space, sheltering from wind and rain.





There are four traffic flow lines outside the venue - the main entrance on the south side (mainly facing the riverside); The entrance near the residential area on the west side (as well as the entrance for guests); To the north is the main entrance six of the sports stadium; The entrance of the sports field on the east side corresponds to the grassy slopes on the east and west sides of the field. The flat form of the building is a complete disappearance, suitable for a site located in the middle. There is a continuous flow line connecting traffic inside the site. The site is divided into two squares and two evacuation points










The continuous spiral space on the ground places crowded activity rooms, businesses, and sports venues below for convenient transportation. These belong to the introverted part. The gym, observation deck, and coffee shop are all built on high ground. Here, it is quieter, with a wider field of vision, and features both introverted and extroverted functionality. The underground part is a reverse spiral space that connects the audience room, athlete changing room, and other auxiliary rooms, with a continuous passage.
Southeast FacadeStadium Unit: Welcome/Enter
Layout Plan 01
The sports stadium has four entrances, each with a function of connecting different areas. After entering the stadium through these entrances, you can quickly choose the area you want to go to. Like a ribbon that connects all around.


Stadium Unit: Welcome/Watch Layout Plan 02

Second
Circulatory System
Stadium Unit:Features/Viewing Layout Plan 03

Circulate Streamline
There are openings in different directions in the base to connect different functional nodes. As the center, the amusement park weakens the solidified sense of space and creates an active space for traffic gathering.
Raising the base to divert traffic further enhances the continuity of the spatial sequence.





EFFECT PICTURE OF RAINY AND SUNNY DAYS

The stadium can open and close more freely under weather conditions, with the aim of allowing the venue to hold events and even concerts under any weather conditions.

An innovative playground for future office spaces
Site:South Korea, Seoul
Individual Work
2023.09-2023.11
When this project explores the unique way of life and work in South Korea, we find it incredible that Koreans spend most of their time in office buildings, even on weekends, which leads to a monotonous and monotonous lifestyle in the region, stifling everyone's creativity and putting heavy pressure on individuals.
In the real transformation, different age groups have lost their cherished childlike innocence and dignity, despite their inner desire for balance. This disconnect between psychological needs and reality has led to the physical decline of amusement parks and the dull atmosphere of office spaces. I hope to reconstruct the human office of the 21st century through exquisite spatial connections and dramatic expressive techniques, and turn the office building into a playground for personal creative design and pursuit of free space.
Driven by minimal structural configuration, we aim to become an open-source playground for future creative professionals to showcase their lives, creating a constantly changing and vibrant utopia of life. This vision aims to overturn tradition and create an exciting new working and living environment for people.






Employees generally believe that through hard work and overtime, they can obtain more career development opportunities and promotion, and hope to achieve better positions and benefits in the workplace.
Many Korean companies have a strong competitive culture, and employee promotions and salary increases are often linked to performance and job performance.
The South Korean education system emphasizes high scores and enrollment rates, which leads to students facing fierce competition from an early age











 Hajun
Doyun
Eunu
Hajun
Doyun
Eunu

























































anxiety Senior executive CEO confused




of inner truth, where people find inner balance and realize their dreams and values.







































































































































































Library+Public Corridor+Elderly Care support
Site:Chiba Prefecture, Japan
Individual Work
2022.12-2023.05
I was inspired by my grandmother, who has been retired for many years and expressed concerns about having little activity in her daily life beyond meals. This prompted me to contemplate the happiness and societal attention given to elderly individuals in their retirement, especially those in vulnerable positions within society. I wondered if individuals who dedicated their youth to urban or societal causes might be forgotten by society in their later years.
During my research, I discovered that many elderly individuals enjoy listening to music through various mediums such as media and radio. They often find that music evokes rich memories, bringing joy and comfort. Music plays a significant role in the lives of the elderly, serving not only as a form of entertainment but also as a means of emotional expression and connecting with past memories.
Therefore, I aim to convey emotions and evoke social resonance through the medium of music. I have designed a community center that incorporates the concept of music, providing activities and services to enhance the lives of elderly individuals.
The first wave of baby boomers
The first wave of baby boomers
The second wave of baby boomers had the highest birth rate



Japan's Defeated Society Returns to Stability





The second wave of baby boomers had the highest birth rate
The government encourages childbearing because of the large number of laborers needed to develop the economy.

The aging of the community is beginning to show
The second wave of baby boomers had the highest birth rate
Social stability, rapid economic growth and a strong desire to have children
Japan's stagnant economy, young people's stress, declining birth rate, aging


Development
FAMILY PENSION
SOCIAL CARE
1970 2015
Japan is an economically developed country. It has basically shifted from a family model of old-age care to a social condition of old-age care. With the Government's promotion, the community model of old age has also made great strides. However, on the whole, the living environment, medical protection and spiritual comfort for the elderly are still lacking. We hope to try out some new modes of ageing to solve this social problem as far as possible.

Japan is a developed country with a developed economy. It has basically changed from a family pension model to a social pension situation. Under the promotion of the government, the community pension model has also achieved great development. Some infrastructure construction has been completed, and the pension status of the elderly has changed significantly. But on the whole, the living environment, medical support, and spiritual comfort of the elderly are also very lacking. We hope to study and try some feasible pension models, and hope to solve this social problem as soon as possible.





Auditory


































"Architecture is frozen music", music is an auditory art in the time dimension, and architecture is a visual art in the space dimension, both of which have a strong appeal. Music reflects the changing space, and architecture has the rhythm of music. The two complement each other beautifully.









ARCHITECTURAL
Space driven relationship diagram
Lecture hall
Exhibition
Event Area
Supermarkets and coffee shops
Dancing and Music Community clinics Service function
Lecture.. public public private communication knowledge community care
Short term accommodation Social function Hotels and Nursing
Interactive Community Center drive employment
Short term residence+activities
Reading aloud and drawing
Elderly people can not only live more conveniently, but also maintain contact with society and spend more vibrant old age.


Balcony

Sunshine Bookstore


The surrounding community can access the Neighbourhood Centre from all directions, the building is lower in height than the surrounding buildings, and plants have been planted around the building and on the roof, which makes the building itself a kind of cityscape.

 Atrium Area
External
Lobby Area
Atrium Area
External
Lobby Area

We have created an elevated space at the entrance, making it a small interactive plaza with an open space that facilitates the exchange of activities.




An entrance is provided on the side of the building to welcome the flow of people from the kindergarten on this side.

We have created a small interactive plaza at the rear to complement the outdoor space.











Individual Work
2024.1-2024.2
In contemporary urban living, indoor air quality has increasingly become a focal point of concern for individuals. With the rising demand for comfortable and healthy living environments, we have discovered a unique and innovative solution – the use of biogenic material Pseudomonas aeruginosa, to elevate indoor air quality to an entirely new level.
This innovative material not only possesses outstanding adsorption capabilities but also effectively absorbs and decomposes harmful substances in the air, such as formaldehyde and benzene, purifying indoor air. The application of this biogenic material is not only a respectful nod to restoring balance in the natural world but also a bold attempt at innovating indoor environments.
I aim to awaken people's awareness of indoor air quality and, through distinctive and innovative design principles, create a living space that prioritizes both health and comfort for modern urban residents.

Industrial Pollution


Traffic Exhaust Energy Production



Industrial emissions and climate pollution have had a significant impact on London



Energy Production




Agricultural Activities


Respiratory tract infection







Can adsorb harmful gases and chemicals in the air.
Pneumonia infection
Wearing a mask when going out
Poor air quality
sodium alginate
activated carbon bacterium
It can have a certain degradation effect on some organic compounds, ammonia, etc. in the air
Flow chart
condensation
dehumidification indoor unit
purify
Breathable materialson
This study explores the application framework between design and biology. Utilize the possibility of biological regeneration and integrate them into the ecological environment.
Firstly, sodium alginate is produced to obtain the initial viscosity. Secondly, activated carbon is added to alginate. Secondly, bacterial culture medium is made to add bacteria to obtain a new material.
Decomposition of biomaterials

The















ALGINATE
ACTIVATED CARBON GERM
The










 Bacteria diffused in the air
Glacier melting
Tree withering
Bacteria diffused in the air
Glacier melting
Tree withering
Through my research and experiments, my goal is to use the inherent properties of sodium alginate and its adhesive effect to bond my subsequent activated carbon and bacteria, mix them in specific proportions, apply pressure to maintain their shape, and complete this process through drying, dehydration, and demolding, which gives it a certain structure.








Five types of sodium alginate, ranging in weight to weight, I used to test their adhesion. And this material will be a component of an unstable structure, which is a stretchable and elastic structure to meet the needs of growth structures. In addition, the characteristics of light, hydrophobicity, or biodegradability in water.















Reaction immersed in water


The particle size of carbon less more more
Activated carbon has the function of adsorbing formaldehyde in the air and it can regulate indoor humidity <5mm 5-20mm >20mm



Sodium alginate glycerol mixed neutral carbon





Fine carbon

Medium carbon













Crude carbon reagent shaping





Less bubbles and good light transmittance



Few bubbles and average light transmittance



Too many bubbles and poor transparency
After conducting experiments, I chose fine carbon because it has the best transparency and the least amount of bubbles. Through the fusion with sodium alginate, I created a new material that can effectively deodorize, eliminate and neutralize indoor odors, and improve the freshness of the air.
Next, I will add Pseudomonas aeruginosa fusion material to better decompose indoor harmful substances such as formaldehyde and benzene, effectively purifying indoor air.

03-A
Culture medium



Bacterial culture
uipment: Agar culture medium, water, vessel uipment: Alcohol lamp, culture dish, bacteria, constant temperature incubator





Sodium alginate glycerol neutral carbon reagent shaping disinfect Streptococcus suis Pour into the culture medium transplant culture


Through my research and experiments, my goal is to use the inherent properties of sodium alginate and its adhesive effect to bond my subsequent activated carbon and bacteria, mix them in specific proportions
03-B
FINAL FORM

Build to simulate how this material can purify and alleviate indoor air quality, and see if it actually has any effect








0 high Measurement value
































